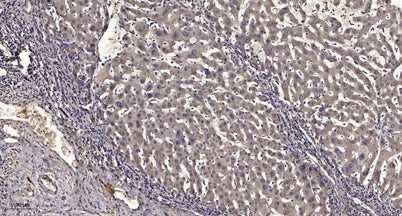
CG059 rabbit pAb

CG059 rabbit pAb
CG059 rabbit pAb
Regular price
$148.00
Sale price
$148.00
Regular price
Shipping calculated at checkout.
Documents
Available in stock (100)
Couldn't load pickup availability
Limited time offer
Get $200 off when you spend $2,500 or more!